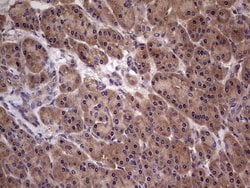
Invitrogen UFD1L Monoclonal Antibody (OTI8G6) 100 &mu;L | Buy Online | Invitrogen&trade; | Fisher Scientific
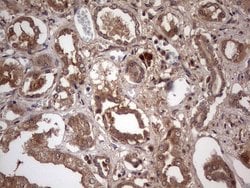
Invitrogen UFD1L Monoclonal Antibody (OTI8G6) 100 &mu;L | Buy Online | Invitrogen&trade; | Fisher Scientific

missing translation for 'onlineSavingsMsg'
Learn More
Learn More
Invitrogen™ UFD1L Monoclonal Antibody (OTI8G6)


Description
UFD1L Monoclonal Antibody for Western Blot, IHC (P)
Ubiquitin-mediated proteolysis requires the transfer of ubiquitin (Ub) to lysine groups on selected cellular proteins, which then potentiates the proteolytic degradation of these protein conjugates by the 26S proteasome. Ub-fusions are cleaved by Ub-specific processing proteases (UBps) or alternatively by the Ub-fusion degradation (UFD) pathway. The UBP pathway targets the C-terminal glycine residue on Ub that is involved in the formation of Ub-conjugates, while UFD proteins preferentially cleave Ub-conjugated proteins that contain an amino acid substitution at this glycine residue. The UFD1 protein was originally characterized in the yeast S. cerevisiae and subsequently, the human homolog UFD1 or UFD1L was identified. In vitro, UFD1 attenuates the degradation of Ub-fusions, which have a proline or valine residue substituted at the Gly76 moiety, by the selective multiubiquitination of the Ub chain of the Ub-conjugate. Mutations within the UFD1 gene are implicated in the development of CATCH22 syndrome, which is characterized by cardiac defects, cleft palate and hypocalcemia, suggesting that this proteolytic pathway may be involved in the progression of these developmental defects.
Specifications
Specifications
| Antigen | UFD1L |
| Applications | Immunohistochemistry (Paraffin), Western Blot |
| Classification | Monoclonal |
| Clone | OTI8G6 |
| Concentration | 1 mg/mL |
| Conjugate | Unconjugated |
| Formulation | PBS with 1% BSA, 50% glycerol and 0.02% sodium azide; pH 7.3 |
| Gene | UFD1 |
| Gene Accession No. | Q92890 |
| Gene Alias | RGD:619822}; UB fusion protein 1; UB fusion protein 1 {ECO:0000250; ubiquitin fusion degradation 1 like; ubiquitin fusion degradation 1 like (yeast); Ubiquitin fusion degradation protein 1; Ubiquitin fusion degradation protein 1 homolog; ubiquitin fusion degradation protein 1 homolog {ECO:0000250; Ubiquitin recognition factor in ER-associated degradation protein 1; UFD1; UFD1L; ufd1l {ECO:0000312; UniProtKB:Q92890} |
| Show More |